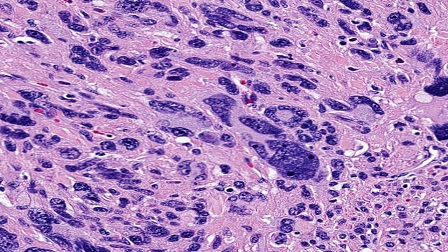
Pleomorphism Versus Monomorphism II

Testing the Spirits

Samuel Smith
23 Jan'19
5
TESTING THE SPIRITS
Once upon a time in the Kingdom of God (Heaven), war broke up. A creature lost his moral compass and overshadowed with pride and greed, stood against his Creator. When he defiled the majesty of God, rejected authority and spoke evil against the heavenly Dignitaries, he lost his authority and power as the archangel. He (Satan) did not prevail as Michael and His angels fought with him nor was a place found for them in heaven any longer (The conception of evil defiled his image as the morning star, and all his prowess and pathos were overshadowed by deceit fraudulence, and diabolism. Instead of honouring his Creator, he wanted to be honoured. Instead of condescending before his Maker, he wanted to ascend above the heights of the clouds and be like the Most High. With all his efforts, he knew that he can never be God so his only accomplishment is to create a counterfeit God (thus to be like God).
As his efforts were impeded by his unprecedented failure in the war in heaven, he carried his dreams down this earth; and human beings became his next target. Can he overtake man in genuineness? NEVER! To succeed demands a careful ploy and dissimulation. In the Garden of Eden, Satan transformed himself as a harmless serpent deceiving our first parents with his fallacies. The first ever false prophecy given on earth was in his first sermon "you will not surely die". Man responded to his alter call, and was baptized into destruction.
Since that time, Satan has been roaming like a roaring lion, seeking whom he may devour. As the serpent became his ambassador in Eden, so has he many apostles today who are sent by him, transforming themselves into apostles of Christ. Like their master, their only means of captivating human mind is to prophecy falsely. As God speak faithfully through His holy prophets, Satan has sent many who professes to be of God but serve not our Lord Jesus Christ, but their belly; and by signs and wonders, miracles and words of prophecy, good words and fair speeches, deceive the heart of the simple (
On this note, Christ's admonishing is that; "many false prophets shall rise and shall deceive many; take heed that no man deceives you" (
Pr. Nicholas Obeng Agyekum